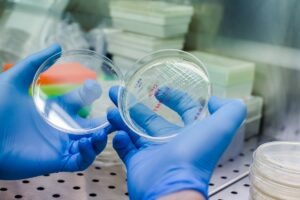
compelo

uBriGene Biosciences has signed a strategic partnership with Cellinfinity BIO to advance the clinical development of in vivo chimeric antigen receptor T-cell (CAR-T) therapy programmes for haematologic and solid tumours.

CIB-301 targets solid tumours using a fully human CAR scFv. Credit: Vshivkova / Shutterstock.com.
Subscribe to our email newsletter
The partnership focuses on progressing Cellinfinity BIO’s programmes CIB-301 and CIB-350.
uBriGene’s LVV Turbo platform will provide good manufacturing practice (GMP) lentiviral vector manufacturing, production, process development, and regulatory support for these therapies.
The platform integrates three technologies: a fully closed downstream purification process, the ultra-T enhancer, and a high-productivity 293TH suspension cell line.
It achieves up to 80% recovery during purification and boosts T-cell transduction titres by five times.
CIB-301 targets solid tumours with a fully human CAR single-chain variable fragment (scFv) designed for low off-target risk.
It addresses tumour antigens related to colorectal cancer, endometrial cancer, non-small cell lung cancer, ovarian cancer, and renal cell carcinoma.
CIB-350 targets autoimmune diseases and haematologic malignancies with a bispecific CAR design able to target two B-cell antigens simultaneously.
uBriGene offers integrated contract development and manufacturing organisation (CDMO) and contract research organisation (CRO) services for cell therapies, viral vectors, and ribonucleic acid (RNA)-related products.
Its global GMP Centers of Excellence support clients in developing next-generation therapies.
Cellinfinity BIO’s platforms focus on precise T-cell modulation for solid tumours, aiming to enhance persistence and safety while demonstrating anti-tumour activity in preclinical models.
uBriGene co-founder and CTO Dr Sun Xiulian said: “We are excited about this strategic partnership with Cellinfinity Bio. In vivo CAR-T technologies have the potential to significantly reduce treatment costs.
“Leveraging our highly productive LVV Turbo lentiviral vector platform and GMP manufacturing expertise, we aim to lower the cost of goods for CAR-T therapies, improving patient accessibility and affordability.”
 Advertise With UsAdvertise on our extensive network of industry websites and newsletters.
Advertise With UsAdvertise on our extensive network of industry websites and newsletters.
 Get the PBR newsletterSign up to our free email to get all the latest PBR
news.
Get the PBR newsletterSign up to our free email to get all the latest PBR
news.